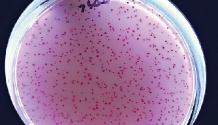

Gausiai gamtos apdovanotas, senomis sveikatinimo tradicijomis garsėjantis modernus kurortas, dvylika mėnesių per metus turintis ką pasiūlyti net išrankiausiems – ir norintiems sustiprėti bei pailsėti, ir nusprendusiems pasimėgauti atostogomis bei išskirtinėmis pramogomis. Taip šiandien sakome apie Druskininkus. Gyvenimas kurorte, kuriame per praėjusius metus apsilankė trečdalis milijono svečių, virte verda. Druskininkiečiai prisipažįsta – sėkmė džiugina, tačiau užmigti ant laurų jie neketina, kurdami ambicingus ateities planus.
Viktorija MITKUTĖ
Šiandien jau sunku patikėti, kad daugiau nei 200 metų istoriją turintis kurortas, laikomas viena patraukliausių sveikatinimo, kultūros ir konferencinio turizmo vietų šalyje, mažiau negu prieš du dešimtmečius buvo atsidūręs ties riba „būti ar nebūti“.
„Žmonės jau netikėjo, kad jų gimtasis miestas atsigaus, nemažai gyventojų nesiejo su juo vilčių ir progai pasitaikius išvažiavo. O tie, kurie nenorėjome nuleisti rankų, tikėjome, kad miestas turi dideles perspektyvas, žinojome ir tai, kad kritinį tašką turime įveikti patys, – prisimindamas tuos laikus, kai stojo prie Druskininkų savivaldybės vairo ir kartu su bend- raminčiais ėmė kurti strategiją, kaip gyventi toliau, pasakoja meras Ričardas Malinauskas (nuotr.). – Mes jau tada nusprendėme, kad būsime visus metus veikiantis kurortas visiems, todėl reikia kurti įvairias paslaugas ir pramogas po stogu, kad jos veiktų nepriklausomai nuo oro ir tiktų visiems – nuo mažo iki pagyvenusio. Tai pasiteisino su kaupu, nes darbo visi turi ne tris keturis mėnesius, o visus metus ir niekam nereikia galvoti, ką veiks rudenį ar žiemą.“
raminčiais ėmė kurti strategiją, kaip gyventi toliau, pasakoja meras Ričardas Malinauskas (nuotr.). – Mes jau tada nusprendėme, kad būsime visus metus veikiantis kurortas visiems, todėl reikia kurti įvairias paslaugas ir pramogas po stogu, kad jos veiktų nepriklausomai nuo oro ir tiktų visiems – nuo mažo iki pagyvenusio. Tai pasiteisino su kaupu, nes darbo visi turi ne tris keturis mėnesius, o visus metus ir niekam nereikia galvoti, ką veiks rudenį ar žiemą.“
Pasak R.Malinausko, tuomet patvirtintų strateginių miesto ir kurorto vystymo krypčių nuosekliai laikomasi, o lūžis įvyko tada, kai savivaldybė, pamačiusi, kad verslas nerizikuos investuoti į vegetuojantį miestą, nusprendė pati imtis darbų, kurie paprastai laikomi verslo prerogatyva, – pradėjo investuoti į kurorto infrast-ruktūrą. O po kelerių kryptingo darbo metų Druskininkų perspektyvomis patikėjo ir verslas.
„Savivaldybė ilgai ieškojo verslininkų, kurie imtųsi įgyvendinti Vandens parko projektą, bet verslas jo nesiėmė. Nusprendėme investuoti patys ir tai padėjo vėliau pritraukti ne vieną dešimtį milijonų eurų kitiems mūsų sumanymams įgyvendinti, – į klausimą, kaip pavyko vėl įsukti ratą, lėmusį, kad šiandien Druskininkų pasiekimais džiaugiasi ne tik kurorto gyventojai, bet ir visa Lietuva, atsako meras ir priduria: – Prieš 10 metų reikėjo įkalbinėti, kad kas nors mieste pardavinėtų ledus, o šiuo metu jau susidarė eilės norinčiųjų mieste teikti dviračių, velomobilių nuomos ir kitas paslaugas.“
Ir svečiams, ir saviems
Kai kuriems Lietuvos regionams sparčiai tuštėjant, o šalies valdžiai ieškant būdų, kaip juos reanimuoti, Druskininkai gali būti pavyzdys, kiek daug gali nuveikti sutelktai dirbdama vietos bendruomenė ir verslas.
Kurorto svečiai, kurių vienu metu Druskininkai gali priimti daugiau kaip 8 tūkst., pamėgo ne tik sveikatinimo procedūras, bet ir aktyviam poilsiui ir pramogoms skirtas erd-ves: lankytojų nestokoja Vandens pramogų parkas, žiemos pramogų kompleksas „Snow Arena“, golfo aikštynas ir kiti pramogų objektai. Kurorto patrauklumą dar labiau padidino vienintelis Lietuvoje ir Baltijos šalyse Lynų kelias, kuriuo iš miesto centro per Nemuną galima persikelti oro gondolomis.
Prieš dvejus metus duris atvėrė atnaujintas istorinis Karolio Dineikos sveikatingumo parkas, kuriame rekonstruotos kaskadinės maudyklės, sutvarkyta parko infrastruktūra, įrengta lauko treniruoklių, vaikų žaidimų aikštelių. Taip pat atnaujinti kiti populiarūs Druskininkų parkai, pavyzdžiui, centre esantis Gydyklų parkas, kurio pagrindine puošmena ir lankomiausia kurorto vieta tapo Druskininkų muzikinis fontanas. Atnaujintas tarp Druskonio ežero ir Vijūnėlės tvenkinio esantis Vijūnėlės parkas, kuris kiekvieną pavasarį visus džiugina įspūdinga narcizų jūra bei japoniškų sakurų žiedais.
Druskininkai – neįgaliesiems draugiškas kurortas. Infrastruktūra, Ilgio ežero paplūdimys pritaikyti negalią turintiems žmonėms, atnaujintame K.Dineikos sveikatingumo parke veikia sūpynės, skirtos judėjimo negalią turintiems žmonėms. Druskininkų vandens parke įrengti keltuvai į baseiną bei specialiai pirtims pritaikytas karščiui atsparus neįgaliojo vežimėlis, „Snow Arena“ neįgaliesiems siūlo išbandyti monoslidę, paslaugų sektoriuje dirbantys verslininkai taip pat atsižvelgė į negalią turinčių svečių poreikius.
„Mums labai svarbu suteikti kuo daugiau įvairių kokybiškų paslaugų ir sudaryti komfortiškas sąlygas kurorto svečiams, nes apie 70–80 proc. verslininkų ir jų sukurtų darbo vietų susijusios su sveikatinimo, apgyvendinimo, poilsio ir kitų paslaugų jiems teikimu, tačiau visomis paslaugomis, kurios siūlomos mūsų svečiams, su specialiais abonementais, suteikiančiais dideles nuolaidas, mielai naudojasi ir vietiniai gyventojai“, – sako R.Malinauskas.
Tai, kad rūpindamiesi kurortu druskininkiečiai neužmiršta ir kaimo gyventojų, liudija čia vykstantys pokyčiai: net 9 iš 10 Druskininkų savivaldybės kaimiškųjų bendruomenių turi naujus, patogius bendruomenės namus!
Druskininkuose – profesionali sporto bazė
Druskininkams augant kartu buvo tobulinama ir kurorto sporto infrastruktūra. Kaip teigia R.Malinauskas, viena iš Druskininkų plėtojimo krypčių – profesionalaus komercinio sporto kryptis, todėl dar 2001 m. įsteigtas šiuolaikiškas sporto centras su keturių šimtų vietų sale žiūrovams, o 2009 m. įrengtas universalus sporto aikštynas su aukščiausią įvertinimą turinčia dirbtinės dangos futbolo aikšte, kurioje gali vykti aukšto rango tarptautinės futbolo varžybos.
Druskininkuose šiuo metu įrenginėjamas visai šalies ir tarptautinei sporto bendruomenei reikšmingas objektas – Sportininkų rengimo centras. Druskininkų savivaldybės taryba, įvertinusi objekto svarbą Lietuvai, centro statybai skyrė žemės sklypą vienoje gražiausių Druskininkų vietų, šalia Ratnyčėlės upės.
Šiuo metu jau įrengta universali sporto salė, 25 m ilgio 8 takų plaukimo baseinas, atskiros dvikovės sporto šakų, bokso, treniruoklių ir kitos salės, įrenginėjamas stadionas, metimo sektorius, viešbutis.
Žiemos sporto mėgėjus visus metus džiugina profesionalios „Snow Arenos“ trasos. Šiai arenai yra išduotas Tarptautinės slidinėjimo federacijos (FIS) pažymėjimas, kuriuo patvirtinama, kad trasa atitinka aukščiausio lygio reikalavimus, o portalas Skiresort.info „Snow Arenai“ suteikė aukščiausią įvertinimą – 5 žvaigždutes.
Visi Druskininkų savivaldybės mokyklų šeštų klasių mokiniai dalyvauja nemokamose slidinėjimo pamokose. Šią programą moksleiviams savivaldybė inicijavo siekdama, kad jaunoji druskininkiečių karta užaugtų pažinusi slidinėjimo galimybes. Programa finansuojama Druskininkų savivaldybės ir „Snow Arenos“ lėšomis.
Druskininkų infrastruktūra puikiai pritaikyta ir tarptautinėms sporto varžyboms. Būtent čia 2021 m. vyks pasaulio lietuvių sporto žaidynės. „Dėl teisės rengti XI pasaulio lietuvių sporto žaidynes varžėsi Palanga, Klaipėda, Birštonas, bet laimėjome mes, nes jau dabar turime puikią sporto bazę, aikštynų, o per ket-verius artimiausius metus taip pat neketiname sėdėti rankų sudėję“, – sako Druskininkų meras R.Malinauskas.
Trūksta tik modernaus Kultūros centro
Druskininkai ne tik džiaugiasi sėkme, bet ir turi ateities planų. Vienas reikšmingiausių projektų – modernus Kultūros centras, kuriame bus galima organizuoti tarptautinius koncertus, teatrų ir kino festivalius, plėtoti konferencinį turizmą. Šiuo metu rengiamas centro techninis projektas. Centrą planuojama įrengti buvusios „Nemuno“ sanatorijos koncertų salės vietoje.
„Konferencinio turizmo srityje Lietuvai dar reikia pasitempti, todėl mes manome, kad tokiems renginiams pritaikyti rūmai Druskininkams būtini. Juose būtų daugiafunkcės didžioji, mažoji ir kino salės, kurios tiktų įvairiems renginiams. Bendra šio projekto vertė – apie 15 mln. eurų ir jam įgyvendinti jau ieškoma finansavimo šaltinių“, – pasakoja R.Malinauskas.
Druskininkiečiai, pasak mero, didžiuojasi, kad iš beveik užmiršto, pensininkų ir įkyrių muselių miesto per keliolika metų Druskininkai sugebėjo vėl tapti mėgstamu kurortu. „Viskas, ką iki šiol druskininkiečiai kantriai dirbdami sukūrė savo rankomis, turi dvejopą pridėtinę vertę: jų gyvenimas tapo kur kas prasmingesnis ir turiningesnis, todėl jie kuria savo ateitį mūsų mieste, o paslaugų kokybe Druskininkai nenusileidžia geriausiems Europos kurortams. Kai pastatysime šiuolaikiškus Kultūros ir kongresų rūmus, bus suformuota visa moderniam kurortui reikalinga infrastruktūra“, – neabejoja meras.
Jau šiemet Druskininkuose pradedama įrenginėti „Menų kalvė“, kurioje menininkai turės patalpas ne tik darbui, bet ir parodoms, prekybai meno dirbiniais. Toliau puoselėjami planai įrengti jūrą po stogu – įgyvendinant šį unikalų projektą būtų išplėstas Druskininkų vandens pramogų parkas ir įrengtas Baltijos jūros kraštovaizdžiui būdingas dirbtinis paplūdimys. Rekonstrukcijos laukia gydyklos, kuriose planuojama teikti lankytojams naujas, dar niekur Lietuvoje neteikiamas paslaugas, planuojama atnaujinti ir kurorto centre esančią pėsčiųjų alėją.
Investuotojų laukia buvusi „Nemuno“ sanatorija ir Druskininkų aerodromas, kurio projektas jau parengtas. Pasak R.Malinausko, šiuo metu aerodrome gali leistis nedideli lėktuvai, galintys tūpti ten, kur nėra specialaus įrengto tako, o Druskininkų tikslas – modernizuoti aerodromą taip, kad jame galėtų leistis nedideli, iki 70 vietų lėktuvai. „Neplanuojame nuolatinių reisų, tačiau užsakomieji reisai būtų dar viena patogi galimybė atvykti pas mus svečiams iš tolimų kraštų. Pavyzdžiui, turistai, atskridę į Varšuvos ar Kijevo oro uostą, pas mus atkeliautų nedideliais užsakomaisiais reisais“, – apie projektą, kuris jau pristatomas įvairiose turizmo parodose ir mugėse, pasakoja R.Malinauskas.